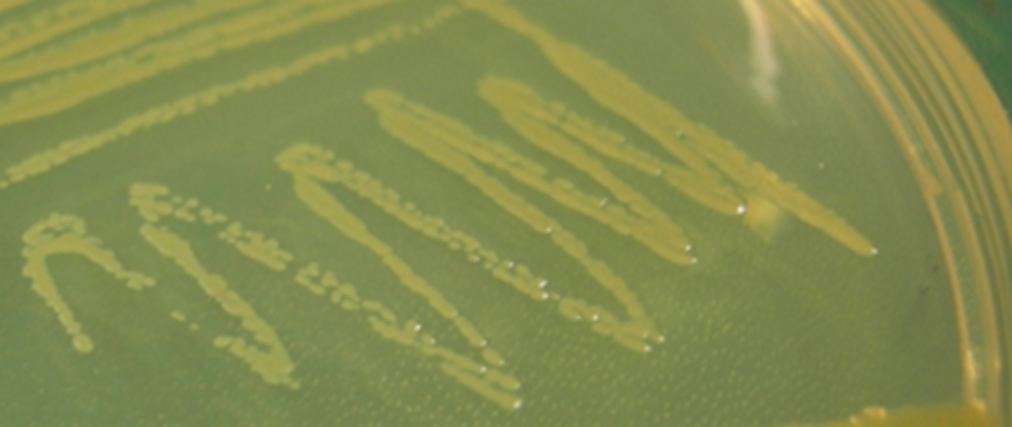

Abstract
Lysobacter capsici strain AZ78 to be used as biocontrol agent against downy mildew of grapevine and potato, possibly in combination with low doses of copper-based products.
Lysobacter capsici strain AZ78 to be used as biocontrol agent against downy mildew of grapevine and potato, possibly in combination with low doses of copper-based products.